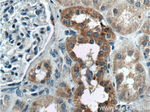
TBC1D24 Antibody in Immunohistochemistry (Paraffin) (IHC (P))

Search
Proteintech
TBC1D24 Polyclonal Antibody
{{$productOrderCtrl.translations['antibody.pdp.commerceCard.promotion.promotions']}}
{{$productOrderCtrl.translations['antibody.pdp.commerceCard.promotion.viewpromo']}}
{{$productOrderCtrl.translations['antibody.pdp.commerceCard.promotion.promocode']}}: {{promo.promoCode}} {{promo.promoTitle}} {{promo.promoDescription}}. {{$productOrderCtrl.translations['antibody.pdp.commerceCard.promotion.learnmore']}}
产品信息
25254-1-AP
种属反应
已发表种属
宿主/亚型
分类
类型
抗原
偶联物
形式
浓度
规格
纯化类型
保存液
内含物
保存条件
运输条件
产品详细信息
Immunogen sequence: MDSPGYNCF VDKDKMDAAI QDLGPKELSC TELQELKQLA RQGYWAQSHA LRGKVYQRLI RDIPCRTVTP DASVYSDIVG KIVGKHSSSC LPLPEFVDNT QVPSYCLNAR GEGAVRKILL CLANQFPDIS FCPALPAVVA LLLHYSIDEA ECFEKACRIL ACNDPGRRLI DQSFLAFESS CMTFGDLVNK YCQAAHKLMV AVSEDVLQVY ADWQRWLFGE LPLCYFARVF DVFLVEGYKV LYRVALAILK FFHKVRAGQP LESDSVKQDI RTFVRDIAKT VSPEKLLEKA FAIRLFSRKE IQLLQMANEK ALKQKGITVK QK (1-321 aa encoded by BC127015)
靶标信息
TBC1D24 may act as a GTPase-activating protein for Rab family protein(s).
仅用于科研。不用于诊断过程。未经明确授权不得转售。
生物信息学
蛋白别名: deafness, autosomal dominant 65; Infantile myoclonic epilepsy; skywalker homolog; TBC/LysM-associated domain containing 6; TBC1 domain family member 24
基因别名: DEE16; DFNA65; DFNB86; DOORS; EIEE16; EIM; EPRPDC; FIME; KIAA1171; TBC1D24; TLDC6
UniProt ID: (Human) Q9ULP9
Entrez Gene ID: (Human) 57465